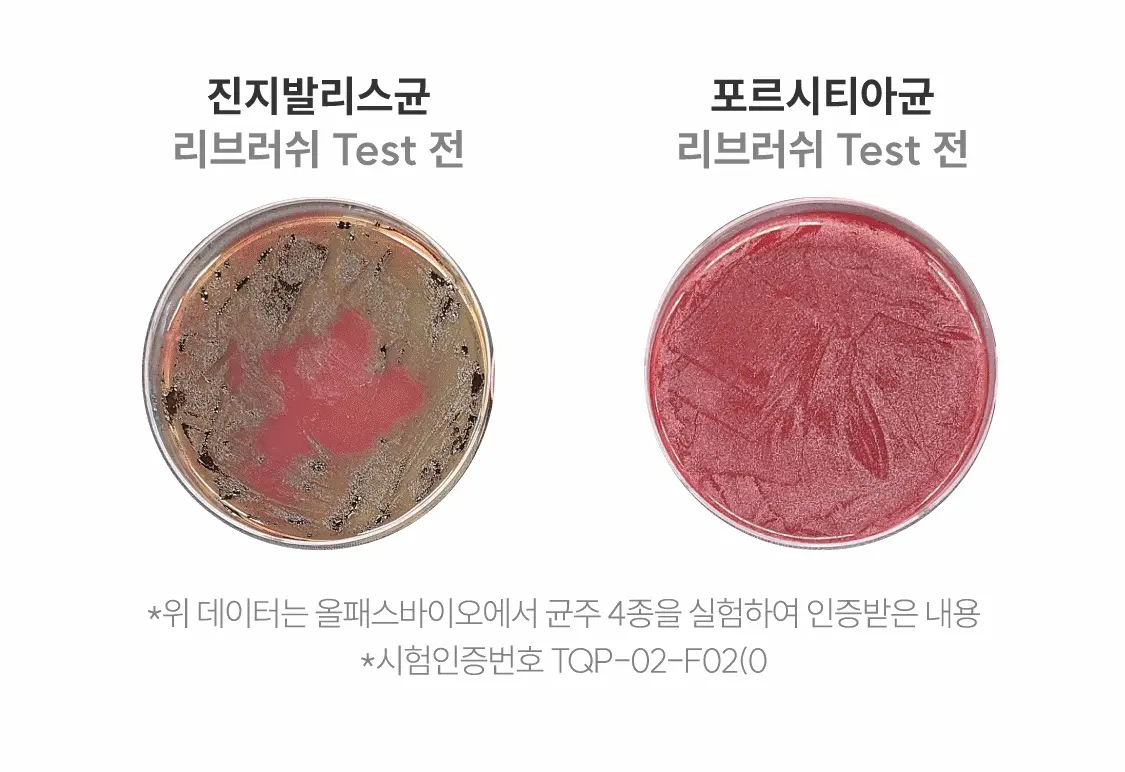
一噴除口臭 不含酒精~Rebrush Fresh Breath Oral Spray 清新口氣除菌隨身口腔噴霧15ml - 2款香味選擇

💡提提你,OMG會員限定優惠有更新!
記得登入/成為會員,享最新會員獨家優惠活動!
Re:Brush 【優惠2送1 SET】一噴除口臭 不含酒精~Rebrush Fresh Breath Oral Spray 清新口氣除菌隨身口腔噴霧15ml – 2款香味選擇
價錢:$99.00 – $219.00
小巧便攜的口腔噴霧,主打無酒精、低刺激與保濕型口腔平衡,為日常清新呼吸提供快速補充。 0% 酒精配方:不含酒精,溫和不刺激,不致使口腔乾燥。 ...more
小巧便攜的口腔噴霧,主打無酒精、低刺激與保濕型口腔平衡,為日常清新呼吸提供快速補充。
- 0% 酒精配方:不含酒精,溫和不刺激,不致使口腔乾燥。
- 口腔益生菌配方:含口腔專用益生菌萃取(Bifidus Extract)1000 ppm,訴求從內部維持口腔平衡。
- 含維他命 C、E:添加維他命 C、E 成分,強調配方支持口腔環境調理。
- 專利成分配方:採用特許成分組合(如丁香 + 迷迭香、以及鋅 + CPC 等配比) 。
- 一支15ml,可用約100+次。
- 多重清新數據:
- 口腔臭味相關細菌去除可達 99.9% 。
- 平均去除口臭氣體 95% 。
- 噴霧後對保濕維持進行 2 小時測試,顯示維持口腔水分效果 。
兩款香味與主要成分
本系列提供兩款風味,可依個人喜好與需求選擇:
- Fresh Breath(檸檬薄荷香)
香味調性:清爽檸檬薄荷,口感偏溫和。
主要成分標示:蜂膠萃取(Propolis Extract)、丁香油(Clove Oil)、Bifidus Extract(口腔益生菌萃取)、Non-Alcohol(無酒精)。 - Refresh(綠茶香 / 薄荷風味)
香味調性:清新綠茶,並以較強的薄荷感帶來更鮮明的清爽感受(較 Fresh Breath 強烈)。
主要成分標示:木糖醇(Xylitol)、綠茶萃取(Green Tea Extract)、積雪草萃取(Centella Asiatica Extract)、Non-Alcohol(無酒精)。
適合使用族群
- 偏好「好味道且溫和」清新口感的人士(選檸檬薄荷款)。
- 需溫和但具有實際口腔保養需求的人士,或對強烈刺激性產品有負擔者。
- 經常飲咖啡、吸煙、或擔心牙齒著色、齒垢問題,想要較強清新感的人。
數據、認證與榮譽
- 產品標示為無酒精(0% Alcohol / Alcohol Free)。
- 原廠標示含口腔益生菌萃取 1000 ppm;含維他命 C、E。
- 具備口腔噴霧成分相關專利 。
- 於通路排名與銷售表現有相關榮譽標示(例如通路排名第一等)。
容量與包裝
- 容量:15 mL(0.50 fl.oz)。
- 攜帶方便,適合放在包內或隨身收納。

我們發現多家商店未獲授權非法盜用本站製作的圖片和文字,本站在此嚴正聲明,本站並沒有在 HKTVMall 或其他平台銷售,只在本站 OhMyGlow.co 銷售,不能保證經其他渠道的貨品來源。
- 以上內容及外盒包裝只供參考用途,商品原廠有更換新包裝權利,一切以實物為準。
- 以上資料及圖片只供參考,一切以實物為準
Re:Brush 產品更多
-19%
Re:Brush \ LeoJ 共同開發 可用100次/ 韓國熱賣 Rebrush Fruit Juice Concentrated Mouthwash 專利100倍濃縮果汁消口氣殺菌便攜漱口液 – 3種口味選擇
價錢:$158.00 Original price was: $158.00.$128.00Current price is: $128.00.
相關產品
-5%
價錢:$38.00 Original price was: $38.00.$36.00Current price is: $36.00.
-52%
🏆皇牌產品
-18%
價錢:$228.00 Original price was: $228.00.$186.00Current price is: $186.00.
-25%
價錢:$128.00 Original price was: $128.00.$96.00Current price is: $96.00.









































































































